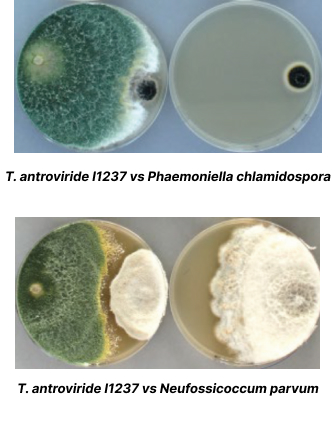

Solución natural a base de Trichoderma atroviride I 1237, rentable y eficaz para prolongar la vida productiva de tus cepas
Mayor tasa de crecimiento en temperaturas <10ºC que hongos patógenos
Reducción de plantas muertas en los primeros 5 años de tratamiento

Diapositiva anterior
Diapositiva siguiente
Diapositiva anterior
Diapositiva siguiente
¿Quieres adquirir el producto?
Contáctanos, nuestro equipo comercial se pondrá en contacto contigo en menos de 24 horas.




